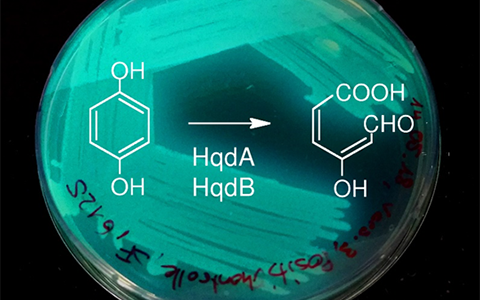

Environmental Biotechnology
The use of microorganisms for the good of the environment.
Environmental biotechnology uses microorganisms and their enzymes to exploit the potential of biological metabolic processes for the benefit of the environment: environmental pollutants are to be disposed of from wastewater and contaminated sites, and natural raw material reserves from waste to be recycled efficiently. The research group "Environmental Biotechnology" tests and develops innovative methods to achieve these goals.
We are working on ways to reduce emissions of pollutants and eliminate existing pollutants. We also develop methods for recycling substances from industrial process water, wastewater and waste. In this way - in addition to economical use of non-renewable resources and the increased use of renewable raw materials - closed material cycles should arise. With the development of new bio-based processes as well as the adaptation and further development of conventional technologies, we contribute to the well-being of the environment and society.